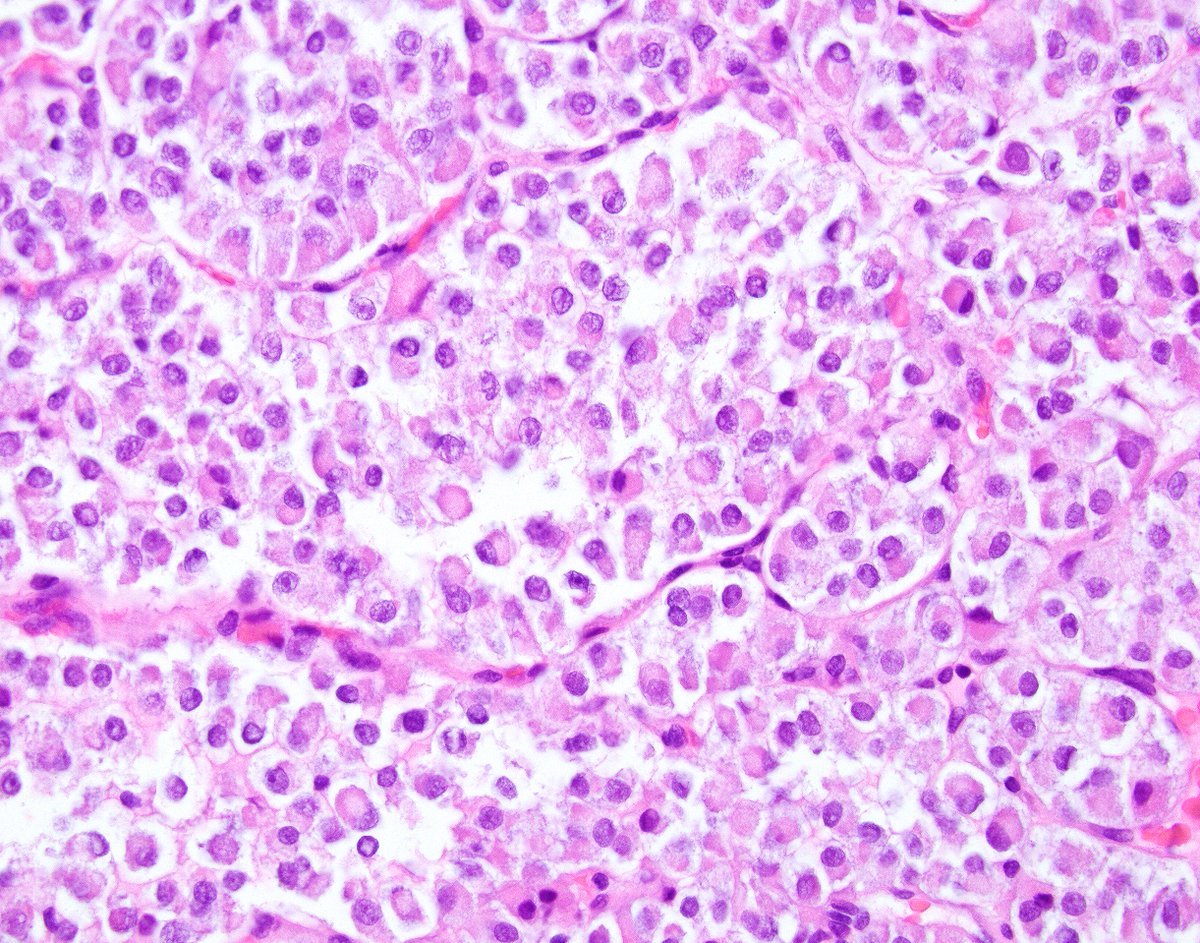
Innovative Science Press tweet media

International Soc of Bone & Soft Tissue Pathology retweetledi

Does This Imaging Make Me Look NFATC2? The Value of... : The American Journal of Surgical Pathology journals.lww.com/ajsp/abstract/…
Check out the figures and the discussion🔥 🔥 🔥
Does this imaging make me look NFATC2?
Props to Dr. Kallen for the title!
This paper is for bone loving pathologists!
#BSTPath
@JHUPath @Greg_Charville @MichaelMichal28 @HopkinsMedicine @mskteachingroom @ctisus @Hopkins_Rad @ISBSTP @reith16
English